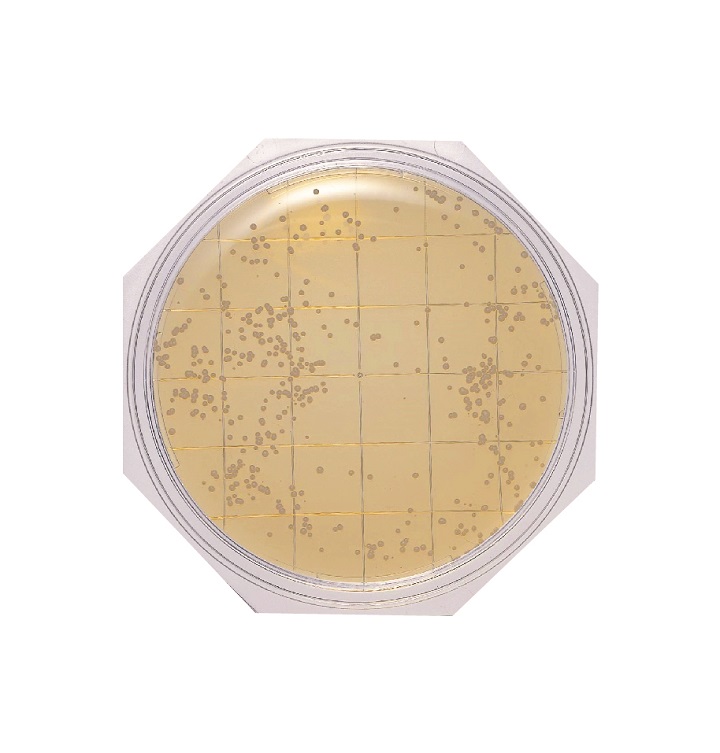
ガンマ線滅菌クリーンスタンプ®25 SCDLP寒天（3重包装・常温） | 食品

日蓮様三点セット 仏像 日蓮宗 日蓮聖人 大黒天 鬼子母神 色付き 彩色 木彫 - 木谷仏壇
(3981件)
Pontaパス特典
サンキュー配送
10440円(税込)
105ポイント(1%)
Pontaパス会員ならさらに+1%ポイント還元!
送料
(
)
3964
配送情報
お届け予定日:2026.05.29 6:6までにお届け
※一部地域・離島につきましては、表示のお届け予定日期間内にお届けできない場合があります。
ロットナンバー
8619456798
お買い物の前にチェック!

Pontaパス会員なら
ポイント+1%
ポイント+1%
商品説明

日蓮様のセットです。値下げも考えております
| カテゴリー: | 本・雑誌・漫画>>>雑誌>>>その他 |
|---|---|
| 商品の状態: | 傷や汚れあり","多くの人が見てわかるような傷や汚れがある |
| 配送料の負担: | 送料込み(出品者負担) |
| 配送の方法: | 佐川急便/日本郵便 |
| 発送元の地域: | 未定 |
| 発送までの日数: | 1~2日で発送 |
レビュー
商品の評価:




 4.8点(3981件)
4.8点(3981件)
- fumi1743
- 何年ぶりでしょう、基礎英語なんて。 中学生の頃を思い出します。 できれば子どもへ、薦めたいのですが なにせ反抗期なものですから言うことは いっさい聞きません。 なので代わりに私がやって側で 偶然でもいいから聴いて欲しいと思って 4月からスタート。 昔と変わらずネイティブの良いこと。 基礎3がちょうどいいレベルで 楽しく毎朝、聴いています。
- kj1231528
- リピート購入です。自分で使ってみて良かったので友人へのプレゼントにも購入しました。年間購読特典のお財布ももらえるみたいです。
- 真優仔
- またカキコすんの忘れてるのらΣ(゚Д゚ υ) これゎおらが解いてるんだけろ簡単なのれ ( *´艸`)オモロぉ〜ッ←ナベアツw あんま悩んで考えてッとハゲるのれ(-_-)゛ (ん・な〜こた〜なぃ) て、言うても最近じぇんじぇん解いてる時間茄子なのれ お正月グゥグゥがんも(ぇ そんなんせんで、おら遊び鯛のら♪
- 愛☆4240
- これは牙狼 金色 攻略のためだけに欲しかった本 なんだけろ、、、 ちっとも攻略じゃ茄子だた本。 確率やらリーチアクションとか?激熱リーチとか? んなもん、知っとるッちゅーの!! まぁ目で楽しむ本だた☆ 実践では29連したのれ別に いいれす( ´ー`)
- ゆはか
- いつだたか? . ランドいら茄子…。なんて言われたぉ(笑) . けろ、買ってるのら(*≧∀≦)ブハッ
- HIRO80031758
- 漢字パズルゎ、おら専用だす(*>∇<)ノ . なんせクロスワードだと簡単すぎて1冊解くのが早くて . 何冊も必要になり、間に合わず(笑) . おらの お財布事情も兼ねて、こちらを♪
- ぽー0484
- クロスワードキングゎ途中から購入しだしたけろ . 意外と解きやすくてオモロ〜♪
- ピチャエル
- 全然、クロスワードのレビューを書いて茄子なのれ . たまりまくり(笑) . また怒涛のクロスワードれびゅスタート♪
- てんてん74143083
- 中1の娘が毎日聞いているので、テキストも毎月購入してます。
- lucky pig mam
- 中1の娘が毎日聞いているので、テキストも毎月購入してます。
- koko7053
- 面白い。 全部の問題が応募出来ないけど、他の雑誌もそう
- シンポチ8376
- 応募できる問題が少ないけど、ナンプレの場合はそうなので仕方ないかな。 面白い
- 腹7分目
- 過去1週間分、スマホでも学習出来るのでいいです。
- ちゃぴ7101
- 見ているだけで、きれいだし、ワクワクした気持ちになります。どんな風に作ろうかな?と色々考えたくなります。とても参考になる本です。
- 白桜ピンク桜
- 本屋が無くなり、本当にありがとうございました。 毎回助かります。
- saakii0531
- 漢字パズルの本は、母と二人でほとんど全種類を発売するたびに購入しています。ちょっとの合間を見て出来る親子のコミュニケーションです。暇つぶしにもなるし、頭の体操にもなるので、これから先もずっと続けていきます。
すべて見る
お店の情報
7,367
連絡・応対
4.3
配送スピード
4.3
梱包
4.3